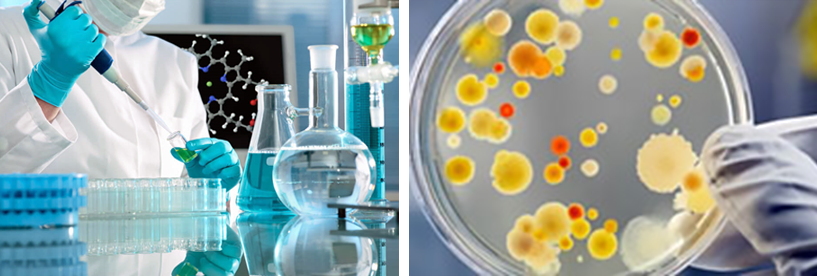

Посада | Ім’я, прізвище | Телефон/Email |
| Начальник науково-випробувальної лабораторії | Світлана ІВАНОВА | (0456) 34-70-62, (050) 853-17-81 lab1@centr.bcdst.kiev.ua |
Науково-випробувальна лабораторія
ДП “КИЇВОБЛСТАНДАРТМЕТРОЛОГІЯ”
Науково-випробувальна лабораторія (НВЛ) являється структурним підрозділом ДП “КИЇВОБЛСТАНДАРТМЕТРОЛОГІЯ”, акредитована в Національному агентстві з акредитації України (НААУ) відповідно до вимог ДСТУ EN ISO/IEC 17025:2019. Сфера акредитації НВЛ дозволяє визначати показники якості та безпеки всієї харчової продукції, продовольчої сировини за органолептичними та фізико-хімічними показниками, вмістом токсичних елементів, пестицидів, харчових добавок, міотоксинів, нітрозамінів, гормональних препаратів, антибіотиків, нітратів, нітритів, гістаміну, радіонуклідів та за мікробіологічними і молекулярно-генетичними показниками (ГМО); посуду за фізико-механічними та радіологічними показниками; мийних та парфумерно-косметичних засобів, засобів особистої гігієни за органолептичними, фізико-хімічними і мікробіологічними показниками та випробування на здатність до біологічного розкладання поверхнево-активних речовин миючих засобів; матеріалів та предметів, що знаходяться в контакті з харчовими продуктами за показниками якості та безпеки; ігор та іграшок за показниками безпечності; спектрометричні та хроматографічні випробування продуктів і матеріалів органічного та неорганічного походження, фізико-механічні випробування будівельних матеріалів, виробів та конструкцій; випробування засобів вимірювальної техніки, обладнання та об’єктів в галузі іонізуючого випромінювання; випробування засобів вимірювальної техніки неавтоматичних зважувальних приладів.
НВЛ отримала право на використання міжнародного Знаку ILAC MRA в поєднанні зі Знаком акредитації НААУ, на підставі “Угоди про використання знаку ILAC MRA” від 30.11.2015, який надає інформацію про те, що лабораторія, яка видає протокол з випробовувань або інший документ, акредитована стороною, що підписала Договір про взаємне визнання ILAC. Договір з ILAC сприяє розвитку міжнародного визнання результатів випробовувань, отриманих в лабораторіях різних країн світу.

ДП “КИЇВОБЛСТАНДАРТМЕТРОЛОГІЯ” дозволяє захищати споживчий ринок від недоброякісної та небезпечної для здоров`я населення продукції. Велика увага при проведенні випробувань надається перевірці якості продуктів з метою недопущення її фальсифікації.
НВЛ ДП “КИЇВОБЛСТАНДАРТМЕТРОЛОГІЯ” єдина в Київській області, що надає послуги з організації виробничих лабораторій, впровадженню окремих, нових для підприємства, видів випробувань на своїх підприємствах, проводить випробовування з метою допомоги вибору найкращого постачальника сировини для підприємств, випробовування з метою визначити “вузьке” місце виробництва, інші консультативні послуги.
• для підтвердження відповідності продукції вимогам законодавчих та нормативно-правових актів, стандартів, регламентів ЄС, державних санітарних норм та правил;
• для підтвердження відповідності складу продукції інформації, яка зазначена на маркуванні;
• для експорту харчової продукції на відповідність вимогам Законодавства ЄС;
• для оцінки якості і безпеки продукції, яка постачається та реалізується в торгівельних мережах та для дегустаційних випробувань продукції власних торгівельних марок;
• на замовлення споживачів та організацій по захисту прав споживачів;
• для контролю продукції з метою виконання державних програм моніторингу з підтвердження відповідності продукції вимогам законодавчо-нормативних документів;
А також, НВЛ проводить міжлабораторні порівняльні випробування, арбітражні випробування, стажування фахівців виробничих випробувальних лабораторій, семінари, консультації та тематичні навчання для працівників підприємств та організацій стосовно нових методів випробування та нормативних документів.

► група токсикологічних випробовувань

► група хроматографічних випробовувань

► група радіологічних випробовувань

► група фізико-хімічних випробовувань

► сектор мікробіологічних випробовувань
Основною діяльністю мікробіологічної лабораторії є проведення випробовувань харчових продуктів та парфумерно-косметичних засобів за мікробіологічними показниками.
• визначення кількості мезофільних аеробних та факультативно-анаеробних мікроорганізмів (МАФАМ);
• визначення бактерій групи кишкових паличок (БГКП).
• визначення Staphylococcus aureus, Proteus, Escherichia coli, Bacillus cereus, Pseudomonas aeruginosa, Clostridium perfringens, сульфітредукуючих клостридій і т. ін.
• визначення патогенних мікроорганізмів, в тому числі бактерій родини Salmonella;
• визначення Listeria monocytogenes.
• визначення дріжджів і плісеневих грибів;
• визначення желатинрозріджуючих бактерій в продуктах, які містять желатин;
• визначення промислової стерильності в усіх видах повних консервів.
Науково-випробувальна лабораторія ДП “КИЇВОБЛСТАНДАРТМЕТРОЛОГІЯ” акредитована в Національному агентстві з акредитації України (НААУ) відповідно до вимог ДСТУ EN ISO/IEC 17025:2019 на компетентність у сфері проведення випробувань бактеріальної забрудненості повітря.
• бактеріологічне дослідження мікробної засіяності об’єктів зовнішнього середовища.
– важливий чинник виробництва безпечних харчових продуктів
Одним з основних завдань харчової та переробної промисловості є виробництво продуктів харчування не лише високої якості, але й цілком безпечних для життя і здоров’я споживача. Цього можна досягти шляхом застосування відповідних технологічних режимів, дотримання вимог виробничих процесів, процедур та інструкцій на всіх етапах виробництва.
Значну загрозу для готової продукції становить виробниче середовище, зокрема:
• неналежний санітарний стан машин і обладнання,
• недотримання правил гігієни,
• мікробіологічне забруднення повітря.
Тому підтримання чистоти і порядку у виробничій зоні мінімізує ризики, пов’язані з мікробіологічним забрудненням харчового продукту. Аналізуючи технологічний процес можна виявити і зосередити увагу на тих ділянках, які могли б сприяти погіршенню мікробіологічної якості продукції.
Небезпеки в харчовій промисловості, які погіршують якість продуктів, можна розділити на три групи: фізичні, хімічні, біологічні. До біологічних забруднювачів відносять хвороботворні мікроорганізми і токсини, які ними виробляються, грибки та їх метаболіти, віруси, паразити.

Технологічні процеси, пов’язані з виробництвом продуктів харчування, не відбуваються в стерильних умовах. Присутність мікробів у навколишньому середовищі очевидна, тому нагляд повинен бути як за сировиною та виробничим процесом, так і за готовою продукцією.
Важливе місце при цьому відводиться аналізу виробничого процесу з метою виявлення місць, які можуть вплинути на появу вторинних інфекцій, оскільки саме вона суттєво збільшує мікробне забруднення кінцевого продукту. Основною причиною такого забруднення є повітря, яке контактує з готовим продуктом. Тип мікроорганізмів в повітрі залежить від характеру навколишнього середовища, однак існує певна група мікробів, які завжди присутні в ньому. Повітряне середовище саме по собі не сприяє розмноженню мікрофлори, однак виступає чудовим переносником зараження. Бактерії в повітря попадають з води, з ґрунту, з відкритих ран живих організмів, їх виділень, з виробничих приміщень тощо.
• бактеріологічне дослідження мікробної засіяності об’єктів зовнішнього середовища (змиви).
Лабораторія молекулярно-генетичних випробовувань створена на базі діючої мікробіологічної лабораторії, спроектована згідно вимог документів МОЗ України і має необхідний набір приміщень, який забезпечує поточність руху досліджуваного матеріалу та укомплектована сучасним устаткованням та тест-системами для ПЛР-дослідження в режимі реального часу. Дослідження на наявність генетично модифікованих організмів (ГМО) рослинного походження проводяться в харчовій продукції та продовольчій сировині.
НВЛ оснащена найсучаснішим високочутливим устаткованням відомих світових виробників.
► сектор випробувань промислових товарів:
• група випробування господарчого посуду, будматеріалів, парфумерно-косметичних засобів та іграшок.
У сферу випробувнь входять:
• вироби керамічні;
• вироби зі скла.
А також посуд:
• фарфоровий та фаянсовий;
• сталевий емальований;
• чавунний емальований;
• з чорних та кольорових металів;
• з короіностійкої сталі;
• з нержавіючої сталі;
• з чорного чавуну;
• з листового алюмінію.
Продукція, що надходить на випробування перевіряється за показниками якості та безпеки.

• Фізико-механічні випробовування (Визначення зовнішнього вигляду, геометричних розмірів, граничних відхилень від розмірів, визначення маси).

• фізичні дослідження.

• органолептичні показники;
• визначення масової частки жирних кислот;
• визначення масової частки вільного лугу;
• визначення масової частки вуглекислого натрію;
• визначення масової частки суми неомилюваних органічних речовин і неомиленого жиру від маси жирних кислот;
• визначення масової частки хлористого натрію;
• визначення масової частки домішок, нерозчинних у воді;
• визначення йодного числа жирних кислот, виділених із мила;
• визначення густини;
• визначення піноутворюючої здатності;
• визначення масової частки поверхнево-активних речовин;
• визначення масової частки гідроокису натрію та вуглекислого натрію;
• визначення стабільності;
• визначення мийної здатності;
• визначення чистильної здатності;
• визначення вмісту етилового спирту;
• визначення масової частки аніонних ПАР;
• визначення здатності до біологічного розкладання;
• визначення масової частки фосфорнокислих солей;
• визначення масової частки активного хлору;
• визначення масової частки запашних речовин, стійкість запаху, прозорість;
• визначення об’ємної та масової частки етилового спирту;
• визначення масової частки ефірної олії;
• визначення покривної здатності;
• визначення показника концентрації водневих іонів (рН);
• визначення масової частки стеаринового цинку або магнію;
• визначення ступеня компактності;
• визначення масової частки води і летких речовин;
• визначення залишку на ситі;
• визначення масової частки гліцерину;
• визначення масової частки загального лугу в перерахунку на КОН;
• визначення колоїдної стабільності, термостабільсті;
• визначення масової частки сухої речовини;
• визначення масової частки хлоридів;
• визначення масової частки перекису водню;
• визначення піноутворюючої здатності;
• визначення температури краплепадіння;
• визначення кислотного числа;
• визначення карбонільного числа;
• визначення вмісту екстрактивних і дубильних речовин;
• визначення вмісту ефірного масла;
• визначення мікробіологічних показників.

• фізичні дослідження;
• токсикологічна оцінка;
• спектрометричні дослідження;
• хімічні дослідження.
Науково-випробувальна лабораторія ДП “КИЇВОБЛСТАНДАРТМЕТРОЛОГІЯ” акредитована в Національному агентстві з акредитації України (НААУ) відповідно до вимог ДСТУ EN ISO/IEC 17025:2019 на компетентність у сфері проведення випробувань засобів вимірювальної техніки, обладнання та об’єктів в галузі іонізуючого випромінювання.

• індивідуальні, пересувні та стаціонарні засоби захисту від іонізуючого випромінення;
• рентгенівські установки (апарати) медичного призначення;
• рентгенівські кабінети, приміщення персоналу та території суміжні з ними;
• гамма установки медичного та технологічного призначення;
• джерела іонізуючого випромінювання;
• будівельні матеріали та мінеральна сировина;
• засоби вимірювальної техніки іонізуючого випромінювання;
• блоки детектування;
• вимірювальні канали систем радіаційного контролю;
• радіометри, радіометричні установки, дозиметри та вимірювачі потужності дози;
• спектрометри альфа-, бета-, гамма-випромінення, спектрометри “Сич”;
• установки сигнальні радіоактивного забруднення і системи контролю рівня радіації;
• випробування засобів вимірювальної техніки неавтоматичних зважувальних приладів.

Науково-випробувальна лабораторія ДП “КИЇВОБЛСТАНДАРТМЕТРОЛОГІЯ” акредитована на проведення випробувань неавтоматичних зважувальних приладів. Неавтоматичний зважувальний прилад (далі — ваги) — засіб вимірювальної техніки, призначений для визначення маси тіла в умовах дії на нього гравітаційних сил, який може використовуватися для визначення інших пов’язаних з масою величин, їх значень, параметрів чи характеристик та потребує участі оператора у процесі зважування.
Ваги застосовуються для здійснення комерційних операцій; для зважування продукції, необхідного для обчислення розміру мита, тарифу, податку, премії, штрафу чи подібних виплат; у медичній практиці для зважування пацієнтів; для виготовлення ліків за рецептами у фармакології, для визначення ціни товарів виходячи з їх маси та в інших випадках. Тому дуже важливо, щоб ваги відповідали метрологічним вимогам, установленим в нормативних документах.
Науково-випробувальна лабораторія проводить випробування згідно ДСТУ EN 45501:2017 ”Метрологічні аспекти неавтоматичних зважувальних приладів” та ДСТУ ГОСТ OIML R 76-1:2014 “Ваги неавтоматичної дії. Частина 1. Метрологічні та технічні вимоги щодо випробувань”.
Еталонна база та кваліфікація персоналу лабораторії дозволяє проводити випробування якісно, на високому рівні і в оптимальні терміни. Це стосується широкого діапазону неавтоматичних зважувальних приладів — від вагів лабораторних високого класу до вагів автомобільних з найбільшою межою зважування 100 т.

Згідно ДСТУ EN ISO/IEC 17025:2019 “Загальні вимоги до компетентності випробувальних і калібрувальних лабораторій”, п. 7.1.3 випробувальна лабораторія ДП “КИЇВОБЛСТАНДАРТМЕТРОЛОГІЯ” проводить оцінку відповідності наданих на випробування зразків вимогам нормативних документів на продукцію з урахуванням невизначеності результатів вимірювання і застосуванням наведеного нижче правила прийняття рішення про відповідність:
• якщо інтервал невизначеності для результату вимірювання міститься всередині області допустимих значень, відповідність вимогам може бути гарантована (висновок – відповідає заданим вимогам);
• якщо інтервал невизначеності для результату вимірювання повністю міститься в області недопустимих значень, можна гарантувати невідповідність вимогам (висновок – не відповідає заданим вимогам);
• якщо інтервал невизначеності для результату вимірювання містить граничне значення, оцінка відповідності не дає змоги беззаперечно стверджувати, що значення характеристики відповідає або не відповідає заданим вимогам (висновок – результат є неостаточним).
Правило відповідає вимогам ДСТУ ISO 10576-1:2006 “Статистичні методи. Настанови щодо оцінювання відповідності заданим вимогам. Частина 1. Загальні положення (ISO 10576-1:2003, IDT)”.
Заявка на укладання договору про надання послуг, у разі необхідності надання НВЛ в протоколі випробування заяви про відповідність зразків продукції вимогам нормативних документів, приймається лабораторією за згоди замовника на використання зазначеного вище правила.
Протоколи випробувань, які видаються науково-випробувальною лабораторію ДП “КИЇВОБЛСТАНДАРТМЕТРОЛОГІЯ” визнаються на міжнародному рівні та є об’єктивним підтвердженням відповідності продукції.
Всіх зацікавлених осіб, підприємців, організацій ВЛ запрошує до співпраці!
Начальник НВЛ — Світлана ІВАНОВА
Тел./факс: (0456) 34-70-62, (050) 853-17-81
Email: lab1@centr.bcdst.kiev.ua



